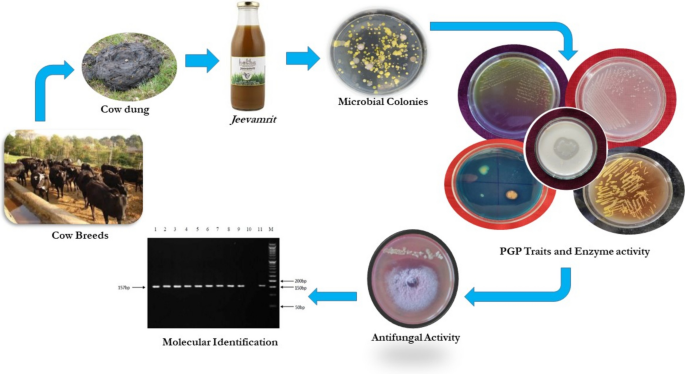

-

生物通官微
陪你抓住生命科技
跳动的脉搏
研究不同牛品种的Jeevamrit生物制剂中的有益微生物群,以促进有机农业系统中植物的环境可持续健康和疾病管理
《Organic Agriculture》:Exploration of beneficial microflora from Jeevamrit bioformulation of different cattle breeds for environmentally sustainable plant health and disease management in organic farming system
【字体: 大 中 小 】 时间:2025年12月19日 来源:Organic Agriculture 2.7
编辑推荐:
Jeevamrit生物制剂中不同牛种微生物群的特征及其植物促生长和抗真菌活性分析。揭示了Pahari非产奶牛样本的N、P、K含量最高,筛选出6株全阳性PGP菌株(除HCN生产),其中Jersey产奶牛分离株抗真菌活性最强,鉴定出E. coli、Klebsiella quasipneumoniae等菌株,首次发现Microbacterium thalassium PL3,为可持续农业提供生物调控方案。
本研究分析了来自不同牛品种的发酵型Jeevamrit生物制剂中的微生物群落,以评估其促进植物生长的特性(PGP)、酶的产生能力以及抗真菌活性。对Jeevamrit的理化分析显示,本土Pahari非泌乳牛中的氮(N)、磷(P)、钾(K)、电导率(EC)和pH值最高。共对48株形态不同的细菌进行了PGP特性和抗真菌活性的研究。无论牛的品种如何,有6株细菌在所有PGP活性测试中均呈阳性反应,仅不产生HCN。定量分析结果显示,来自Jersey非泌乳牛的细菌在磷酸盐溶解能力方面表现最佳(125.02 ± 5.90 μg/ml),而来自Jersey泌乳牛的细菌在铁载体产生能力方面表现最佳(92.35 ± 5.68%);来自Pahari泌乳牛的细菌在IAA产生能力方面表现最佳(76.05 ± 3.50 μg/ml)。在对抗Rhizoctonia solani、Sclerotonia sclerotiorum、Pythium aphanidermatum、Phytophthora属菌、Alternaria alternata和Fusarium oxysporum的真菌活性方面,来自Jersey泌乳牛的细菌具有最强的抗真菌能力。根据PGP、酶活性和抗真菌活性,共鉴定出6株具有潜在价值的细菌。其中,来自Jersey品种的J JL2和J JL8两株细菌被鉴定为Escherichia coli;来自Pahari和Jersey泌乳品种的JPL6和J JL7两株细菌属于Klebsiella quasipneumoniae;来自Jersey干奶牛品种的JJD2被鉴定为Sphingobacterium multivorum;而来自Pahari泌乳品种的JPL7与Enterobacter cloacae的相似性最高。这6株潜在有价值的细菌均是从不同牛品种制备的Jeevamrit生物制剂中分离得到的,而Microbacterium thalassium PL3菌株则是首次从Pahari泌乳牛的粪便中分离出来的。这些来自不同牛品种的潜在菌株可通过单独使用、联合使用或与生物制剂结合的方式,以环境可持续的方式促进植物健康并管理植物疾病。

本研究分析了来自不同牛品种的发酵型Jeevamrit生物制剂中的微生物群落,以评估其促进植物生长的特性(PGP)、酶的产生能力以及抗真菌活性。对Jeevamrit的理化分析显示,本土Pahari非泌乳牛中的氮(N)、磷(P)、钾(K)、电导率(EC)和pH值最高。共对48株形态不同的细菌进行了PGP特性和抗真菌活性的研究。无论牛的品种如何,有6株细菌在所有PGP活性测试中均呈阳性反应,仅不产生HCN。定量分析结果显示,来自Jersey非泌乳牛的细菌在磷酸盐溶解能力方面表现最佳(125.02 ± 5.90 μg/ml),而来自Jersey泌乳牛的细菌在铁载体产生能力方面表现最佳(92.35 ± 5.68%);来自Pahari泌乳牛的细菌在IAA产生能力方面表现最佳(76.05 ± 3.50 μg/ml)。在对抗Rhizoctonia solani、Sclerotonia sclerotiorum、Pythium aphanidermatum、Phytophthora属菌、Alternaria alternata和Fusarium oxysporum的真菌活性方面,来自Jersey泌乳牛的细菌具有最强的抗真菌能力。根据PGP、酶活性和抗真菌活性,共鉴定出6株具有潜在价值的细菌。其中,来自Jersey品种的J JL2和J JL8两株细菌被鉴定为Escherichia coli;来自Pahari和Jersey泌乳品种的JPL6和J JL7两株细菌属于Klebsiella quasipneumoniae;来自Jersey干奶牛品种的JJD2被鉴定为Sphingobacterium multivorum;而来自Pahari泌乳品种的JPL7与Enterobacter cloacae的相似性最高。这6株潜在有价值的细菌均是从不同牛品种制备的Jeevamrit生物制剂中分离得到的,而Microbacterium thalassium PL3菌株则是首次从Pahari泌乳牛的粪便中分离出来的。这些来自不同牛品种的潜在菌株可通过单独使用、联合使用或与生物制剂结合的方式,以环境可持续的方式促进植物健康并管理植物疾病。
生物通微信公众号
生物通微信公众号
知名企业招聘